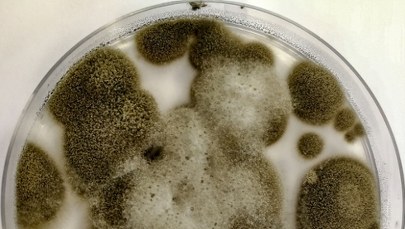
Grzyb z Czarnobyla zaskoczył naukowców. Budzi zainteresowanie agencji kosmicznych

Pierwszy test nowej chińskiej rakiety wielokrotnego użytku Zhuque-3 firmy LandSpace zakończył się w środę niepowodzeniem - podał Reuters, powołując się na chińską państwową agencję informacyjną Xinhua. Podczas sprowadzania maszyny na Ziemię doszło do nieprawidłowego spalania paliwa, co uniemożliwiło miękkie lądowanie. Mimo porażki to jeden z najbardziej zaawansowanych projektów w branży technologii kosmicznych, który w przyszłości może konkurować z amerykańskimi liderami, jak SpaceX Elona Muska czy Blue Origin Jeffa Bezosa.
- Firma LandSpace przeprowadziła w środę pierwszy test rakiety wielokrotnego użytku Zhuque-3.
- Podczas próby kontrolowanego lądowania doszło do nieprawidłowego spalania paliwa, co zakończyło test niepowodzeniem.
- LandSpace dąży do globalnej ekspansji w branży technologii kosmicznych, a sukces rakiety Zhuque-3 mógłby znacznie wzmocnić pozycję firmy w konkurencji z - wciąż silniejszymi - amerykańskimi liderami.
- Więcej aktualnych informacji znajdziesz na stronie głównej RMF24.pl.
Chińska firma LandSpace przeprowadziła w środę pierwszy lot testowy rakiety wielokrotnego użytku Zhuque-3 - przekazała agencja Reutera, powołując się na państwową agencję infromacyjną Xinhua. Jednak podczas próby kontrolowanego lądowania doszło do nieprawidłowego spalania paliwa, co uniemożliwiło miękkie lądowanie. Przyczyny awarii są obecnie wyjaśniane.
Niepowodzenie to podkreśla, jak trudne jest opracowanie rakiety, którą można nie tylko wynieść na orbitę, ale także bezpiecznie sprowadzić na Ziemię i częściowo ponownie wykorzystać. Dotychczas taką technologię opracowały jedynie amerykańskie przedsiębiorstwa - SpaceX Elona Muska i Blue Origin Jeffa Bezosa. To jednak SpaceX regularnie wykorzystuje tę przełomową technologię w swojej rakiecie Falcon 9.
Nieudany test nie zmienia jednak pozycji firmy LandSpace, która pozostaje w czołówce chińskich firm pracujących nad tego typu rozwiązaniami. Dopracowanie rakiety Zhuque-3 do stanu, w którym będzie mogła konkurować z amerykańskimi odpowiednikami, może stanowić przełom w branży za sprawą pojawienia się nowego, dużego gracza.
Wprowadzenie rakiet wielokrotnego użytku na rynek pozwoliłoby na szybszą i tańszą niż obecnie realizację misji. W efekcie znacząco przyspieszyłoby to rozwój chińskiego przemysłu technicznego. To kluczowe aspekty w kontekście planów Pekinu dotyczących rozmieszczenia dużych instalacji satelitarnych. Celem Państwa Środka jest stworzenie systemu, który mógłby konkurować przede wszystkim z amerykańskim systemem internetu satelitarnego Starlink, należącym do SpaceX.
Firma Elona Muska zrewolucjonizowała branżę kosmiczną, wprowadzając rakietę Falcon 9, której część może być wielokrotnie wykorzystywana. Pozwoliło to SpaceX na wynoszenie satelitów szybciej i taniej, niż pozwalały na to wcześniejsze technologie, czyniąc ją liderem globalnego rynku. Chińskie firmy, takie jak LandSpace, starają się powtórzyć ten sukces, jednak droga do osiągnięcia podobnego poziomu efektywności - jak pokazał środowy test Zhuque-3 - jest jeszcze długa.